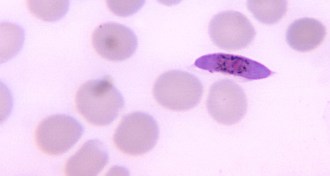

Beth Mole

Trustworthy journalism comes at a price.
Scientists and journalists share a core belief in questioning, observing and verifying to reach the truth. Science News reports on crucial research and discovery across science disciplines. We need your financial support to make it happen – every contribution makes a difference.
All Stories by Beth Mole
-
 Chemistry
ChemistryAncient bond holds life together, literally
The chemical link between sulfur and nitrogen in animal tissues and organs may have sparked the assembly of single cells into complex animals.
-
 Microbes
MicrobesVirus-thwarting mosquitoes decline on Vietnamese island
Scientists plan to release second generation of mosquitoes that stop the spread of dengue fever.
-
 Materials Science
Materials ScienceNanoglue attaches tissues to each other
Silica particles could repair and help engineer human organs.
-
 Neuroscience
NeuroscienceFaulty brain wiring may contribute to dyslexia
Adults with the disorder showed difficulty transmitting information among areas that process language.
-

-
Life
LifeCompounds defeat malaria at every step
Experimental drugs are first to kill all stages of the parasite’s infection cycle.
-
 Materials Science
Materials ScienceMaterial inspired by dragonfly wings bursts bacteria
Silicon studded with nanostructures could act as antimicrobial coating on medical devices.
-
 Agriculture
AgricultureProbiotics may protect piglets from E. coli infection
Beneficial bacteria could replace antibiotics in pig feed.
-
 Ecosystems
EcosystemsVirus-blocking insects taking over Vietnamese island
Field trial tests mosquitoes that may stop the spread of dengue infection.
-
 Earth
EarthFire may smolder under Antarctic ice
Quakes hint at moving magma that could influence glacial flow.
-
 Science & Society
Science & SocietyScience slowdown
The recent federal government shutdown, which furloughed more than 800,000 government workers and may have cost the nation as much as $24 billion, has sent ripples through the nation’s scientific research enterprise.
-
 Life
LifeHow to kill the last microbes standing
Chemical wipes out bacteria that linger after antibiotic treatment.